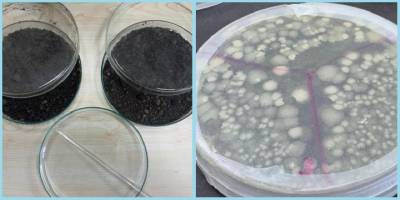
Petrolle kirlenmiş topraklar deniz bakterileriyle temizleniyor

DOĞU ANTARKTİKA'DAKİ BUZULLARIN ERİMESİ ADA ÜLKELERİNİ TEHDİT EDİYOR
İTÜ, "RV SERMET" GEMİSİYLE, MARMARA VE EGE'DE AKTİF FAYLARI İNCELEYECEK
BALIĞIN TAZELİK DERECESİNİ GÖSTEREN ÖLÇÜM CİHAZINA "BULUŞ" TESCİLİ
YERLİ ÜRETİM SUALTI SCOOTER: TUNAPRO
MARMARA DENİZİ'NDE KİRLİLİĞİN JEOLOJİK KAYITLARDA BIRAKTIĞI İZLER ARAŞTIRILIYOR
DENİZ MADENCİLİĞİ TÜM DENİZ CANLILARINI OLUMSUZ ETKİLEYEBİLİR
36 ŞEHİR SULAR ALTINDA KALABİLİR!
PASİFİK'TE SESSİZ FELAKET: DÜNYA KABUĞU PARÇALANIYOR
MERCAN RESİFLERİ İKLİM KRİZİNİN GÖLGESİNDE YOK OLUYOR
DENİZ TABANINDA CANLI TESPİTİ İÇİN YAPAY ZEKA KULLANILMAYA BAŞLANDI